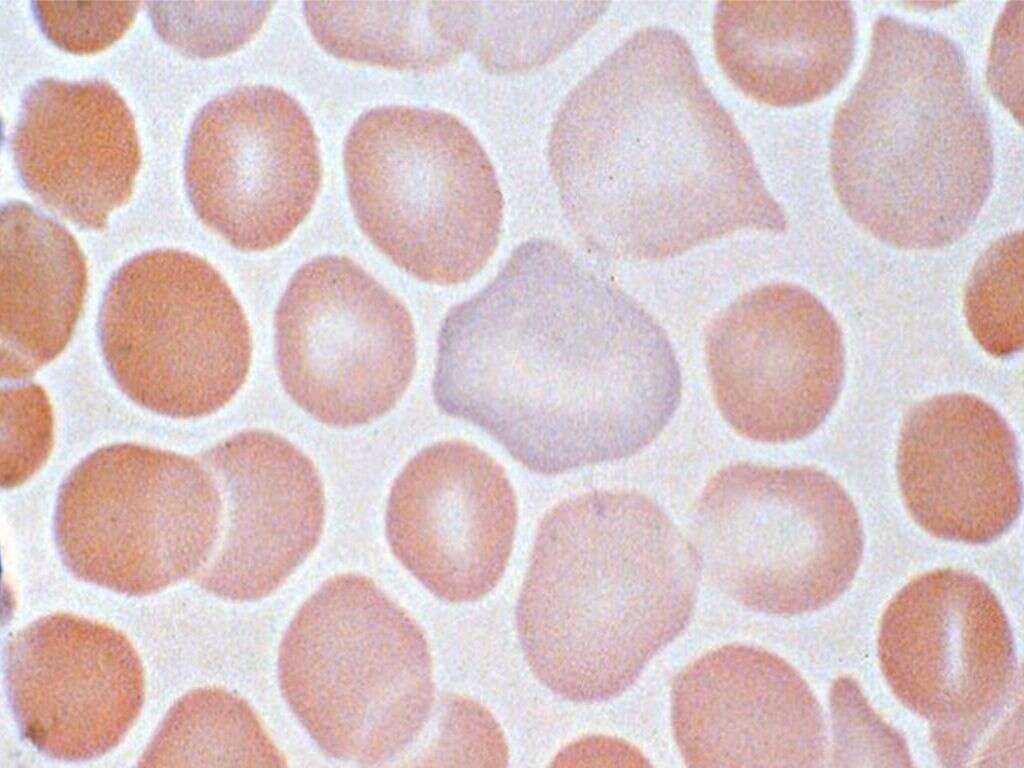

What Is Aplastic Anemia?
In general, anemia is a condition wherein you don’t produce enough red blood cells to properly oxygenate your body. Some anemia is caused by low iron count or sickle cell disease. Aplastic anemia is another condition that lowers your count of healthy red blood cells.
Aplastic anemia is a rare condition. It may appear suddenly or it may come on gradually, lying dormant for years before you notice its effects. You may have time to schedule an appointment with your primary care physician, or you may need to go to the emergency room if symptoms appear abruptly or seem life threatening. Here is some information to help you determine the best course of action to take.
1. What Are the Symptoms of Aplastic Anemia?
Some people with aplastic anemia are asymptomatic, but many experience a significant amount of fatigue. Other initial symptoms include headache, fever, shortness of breath, dizziness and skin rashes. You may also experience a rapid or irregular heartbeat. Pale skin, unexplained bruising and nosebleeds are also common.
While these symptoms are troublesome, the real threat that comes with aplastic anemia is a compromised immune system. If you get an infection, it may take longer than usual to heal. You may find that your blood doesn’t clot as quickly when you get cut. Anemia affects the body’s overall ability to defend itself.
2. What Causes Aplastic Anemia?
Aplastic anemia occurs when the stem cells in your bone marrow are damaged. This can affect the production of platelets, red blood cells and white blood cells. Interruption to this production renders your blood less able to deliver oxygen to all your organs, fight infection and clot.
Your own immune system is often the culprit if it attacks stem cells in your bone marrow. An existing autoimmune disorder could be the problem. Toxic chemicals used in pesticides, gasoline, chemotherapy and some medications can lead to aplastic anemia, as can a viral infection such as hepatitis or Epstein-Barr.
3. What Factors Increase the Risk of Aplastic Anemia?
It logically follows that some of the risk factors of aplastic anemia involve exposures to toxins known to cause it. If you frequently come into contact with insecticides or paint removers, you may increase your risk of becoming anemic. Those undergoing cancer treatments, particularly radiation or chemotherapy, often suffer aplastic anemia as a side effect.
In rare instances, pregnant women may be at higher risk for aplastic anemia, particularly if they have a compromised immune system. If you have rheumatoid arthritis, your medication may increase your chances of aplastic anemia.
4. What Disorders Are Associated With Aplastic Anemia?
Other types of anemia can lead to or exacerbate aplastic anemia. Fanconi anemia, for example, is a genetic issue that has many of the general symptoms of anemia but also slows children’s development, particularly as they enter puberty.
Any disease that affects the production or health of red blood cells can also cause or be complicated by aplastic anemia. For example, paroxysmal nocturnal hemoglobinuria is a rare blood disorder that causes red blood cells to deteriorate. If you are not producing enough of these cells to begin with, PNH can cause you to become anemic or increase the severity of its symptoms.
5. What Information Will Your Doctor Need to Diagnose You?
If you are showing signs of aplastic anemia, don’t ignore them. If they are severe, you may need to go to the emergency room. Otherwise, make an appointment with your doctor.
Before you arrive for your appointment, write down as many specific details as you can remember. When did your symptoms first appear? What medications are you taking? Have you recently been exposed to new chemicals or an environment where they could possibly be present? The more information you can give your doctor, the more likely you are to get an accurate diagnosis.
6. How Is Aplastic Anemia Diagnosed?
There are two basic tests your doctor may run to diagnose aplastic anemia. The first is a simple blood test. This test gauges the levels of red blood cells, platelets and white blood cells to determine if they are in the normal range.
The second test your doctor may order is a biopsy of your bone marrow. A small amount of bone marrow is extracted and studied. The results can determine the number of blood cells in your bone marrow and help rule out other blood disorders so that treatment can be more focused.
7. What Treatment Options Are Available?
The most effective long-term solution to aplastic anemia is a bone marrow transplant. Healthy stem cells from a matching donor are injected into your bloodstream and make their way into your bone marrow. If the transplant is successful, these stem cells can help your bone marrow function the way it’s supposed to function.
For many people, a bone marrow transplant isn’t a viable option, and some transplants are rejected. Bone marrow stimulants may spark production. Antiviral or antibiotic medication can improve immunity to fight the symptoms of aplastic anemia. Immunosuppressants may keep your immune system from attacking stem cells. Blood transfusions can be used to temporarily relieve fatigue.
8. What Does Living with Aplastic Anemia Look Like?
Most people with aplastic anemia must learn to live with it, managing symptoms as best as they can. The best thing you can do for your body is rest. Fight the urge to power through the fatigue, as this can make you more susceptible to complications. You may have to adjust your schedule significantly to account for your lower energy levels.
Since anemia makes it more difficult to heal, it is a good idea to avoid situations where you are at greater risk of injury or contagious disease. Avoid contact sports. Wash your hands more frequently and don’t ignore symptoms of illness.
9. How Can Your Family Support You?
As with any chronic condition, social support is important. Your family and friends can provide emotional support or volunteer to take on tasks that you can no longer handle. They may also help you find support groups in your area with people who understand exactly what you’re going through.
Another way they can support you is by signing up to be a blood marrow donor. Even if they are not a match for you, they may be a match for someone else, or they can help raise awareness that eventually leads to a match for you.
10. How Can You Learn More About Aplastic Anemia?
Your doctor is your primary source of good information. If you have questions about your symptoms or your treatment options don’t seem to be working, don’t be afraid to ask your primary care physician.
You can also learn a lot about your condition online. A quick search can point you toward the answers you need. Gathering more knowledge can help you manage your symptoms more effectively.